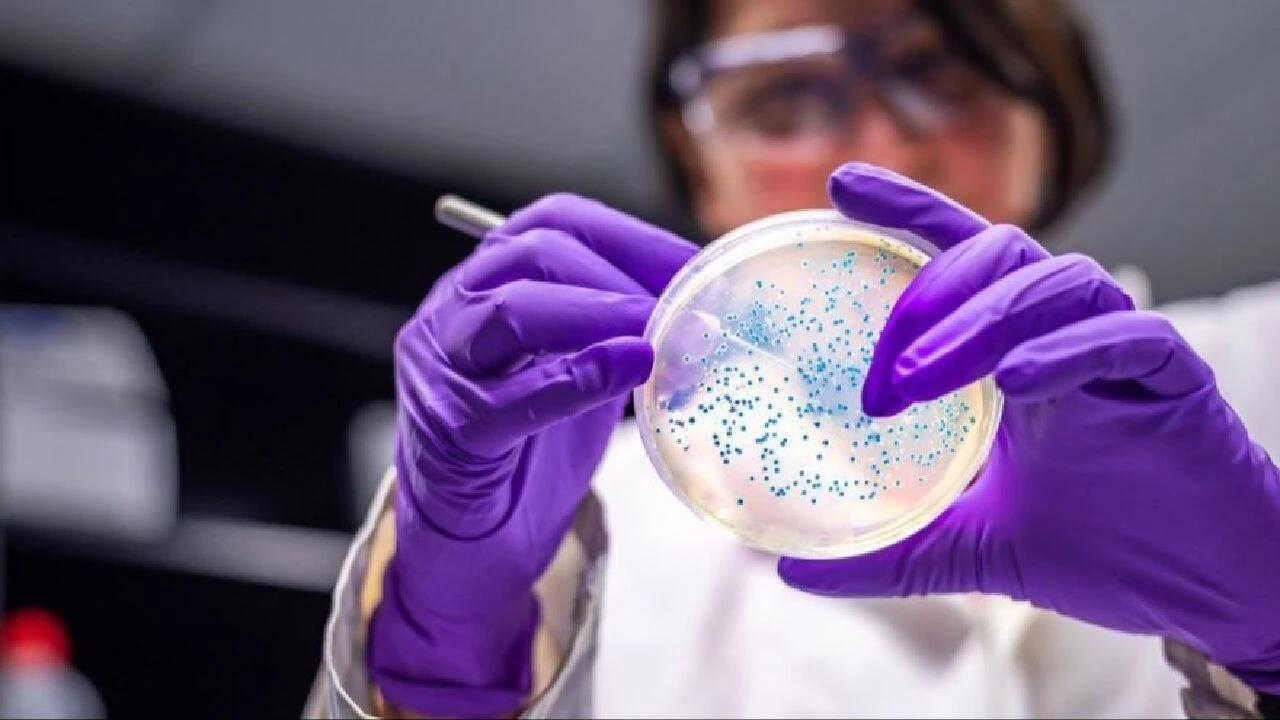

Kategoriler
UYGULAMALAR
İstanbul

Araştırmaya göre, evdeki el yıkama lavaboları tehlikeli mikropların ürediği "sıcak noktalar" arasında yer alıyor. Bu mikroplar arasında zatürre, lejyoner hastalığı ve yara enfeksiyonlarına neden olabilen bakteriler de bulunuyor.
Araştırmacılar, hastanelerde ve evlerdeki lavabolarda oluşan biyofilmleri (lavaboların giderlerinde ve muslukların etrafında bulunan yapışkan ve kaygan bir madde) inceledi. Bu maddelerin içinde insan sağlığına ciddi zarar verebilecek mikropların yaşadığı tespit edildi.

Çalışmanın başyazarı Claire Hayward, "Her iki ortamda da, tipik olarak suda taşınmayanlar da dahil olmak üzere, yüksek miktarda patojenik ve aşındırıcı mikrop bulduk." ifadesini kullandı.
Araştırmacılar, bu patojenlerin biyofilme muhtemelen lavaboyu el yıkamak için kullanan insanlardan, gelen su kaynağından veya biyolojik atık yoluyla aktarıldığını düşünüyor.

Bununla birlikte eğer hastanelerdeki lavaboların evdekilerden daha fazla mikrop barındırdığını düşünüyorsanız yanılıyorsanız. Zira Dr. Harriet Whiley'e göre evlerdeki lavabolardaki biyofilmlerde, hastanelerdekine kıyasla daha fazla bakteri tespit ettiklerini belirtti.
Konutlardan alınan örneklerde, hastanelerden alınanlara kıyasla daha fazla sayıda Legionella bakterisi mevcuttu. Ekibe göre, hastane lavaboları muhtemelen evdeki lavabolardan daha sık ve daha kapsamlı bir şekilde temizleniyor.
Hayward, "Mikrobiyal toplulukların çeşitliliğindeki farklılık, sağlık hizmetleri enfeksiyon kontrol uygulamalarının hayata geçirilmesiyle hastanelerdeki lavaboların daha düzenli temizlenmesi, kullanılması ve tasarlanmasından kaynaklanıyor olabilir." diyerek durumu açıkladı.
Ayrıca bu durumun, sağlık sistemi üzerindeki yükü azaltmak için hastanede yatarak tedavi görmeye alternatif olarak ortaya çıkan evde sağlık hizmeti alan hastalar için de risk oluşturduğunu kaydetti.